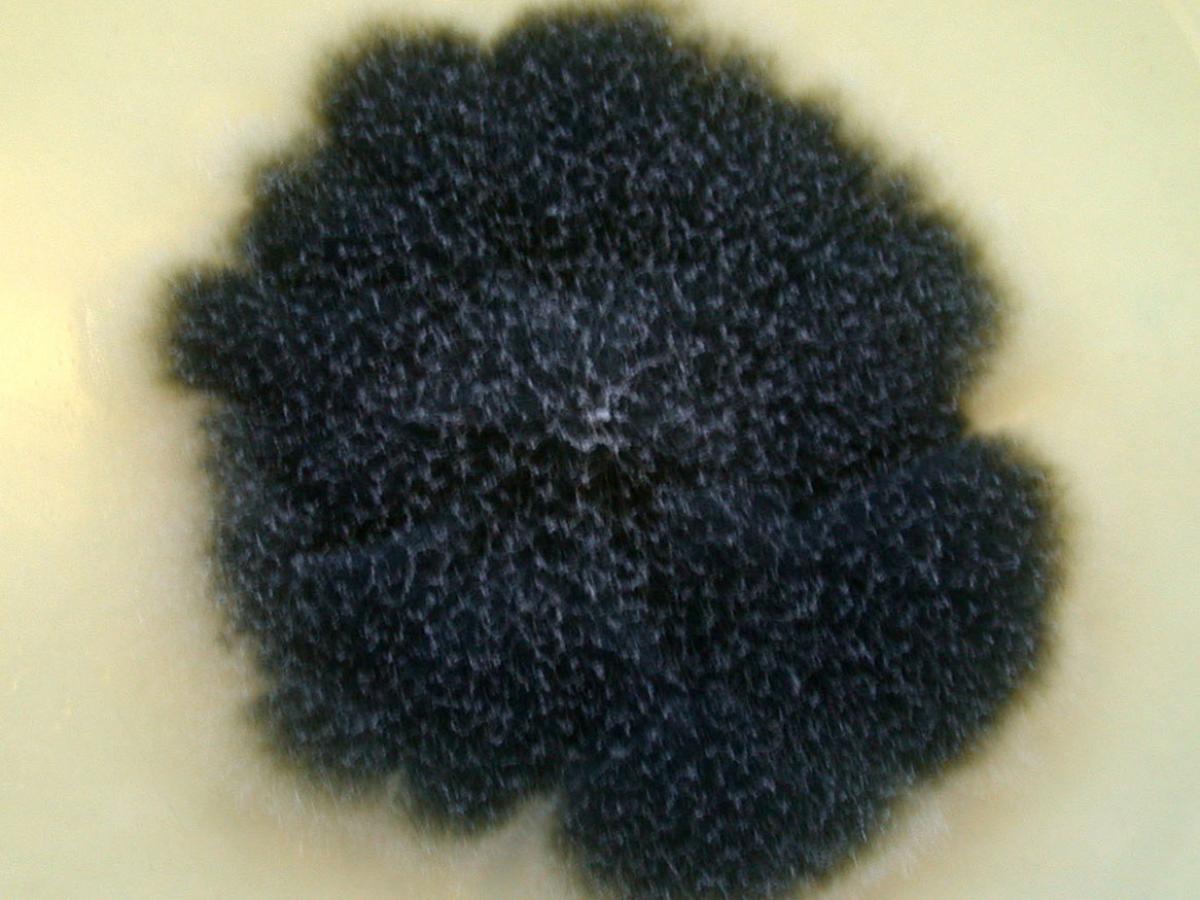
Culture

Unknown 76
Mould identification: a virtual self assessment
Case history
A nasal swab taken from a patient with a history of sinusitis and nasal polyps grew the fungus shown below.

Culture

Microscopy
Mould identification: a virtual self assessment
Case history
A nasal swab taken from a patient with a history of sinusitis and nasal polyps grew the fungus shown below.
Culture

Microscopy